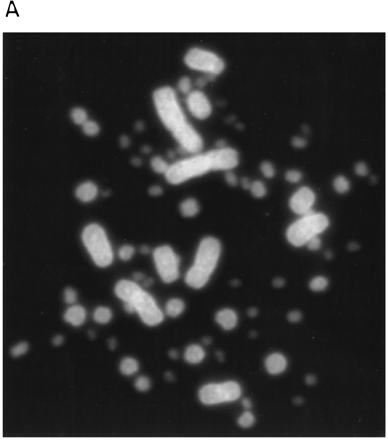
Figure 2.

Figure 2.
PRINS hybridization of a (CA)10 oligonucleotide to a female chicken metaphase spread. (A) Chromosomes were counterstained with DAPI. (B) (CA)10 hybridization in the absence of DAPI staining











